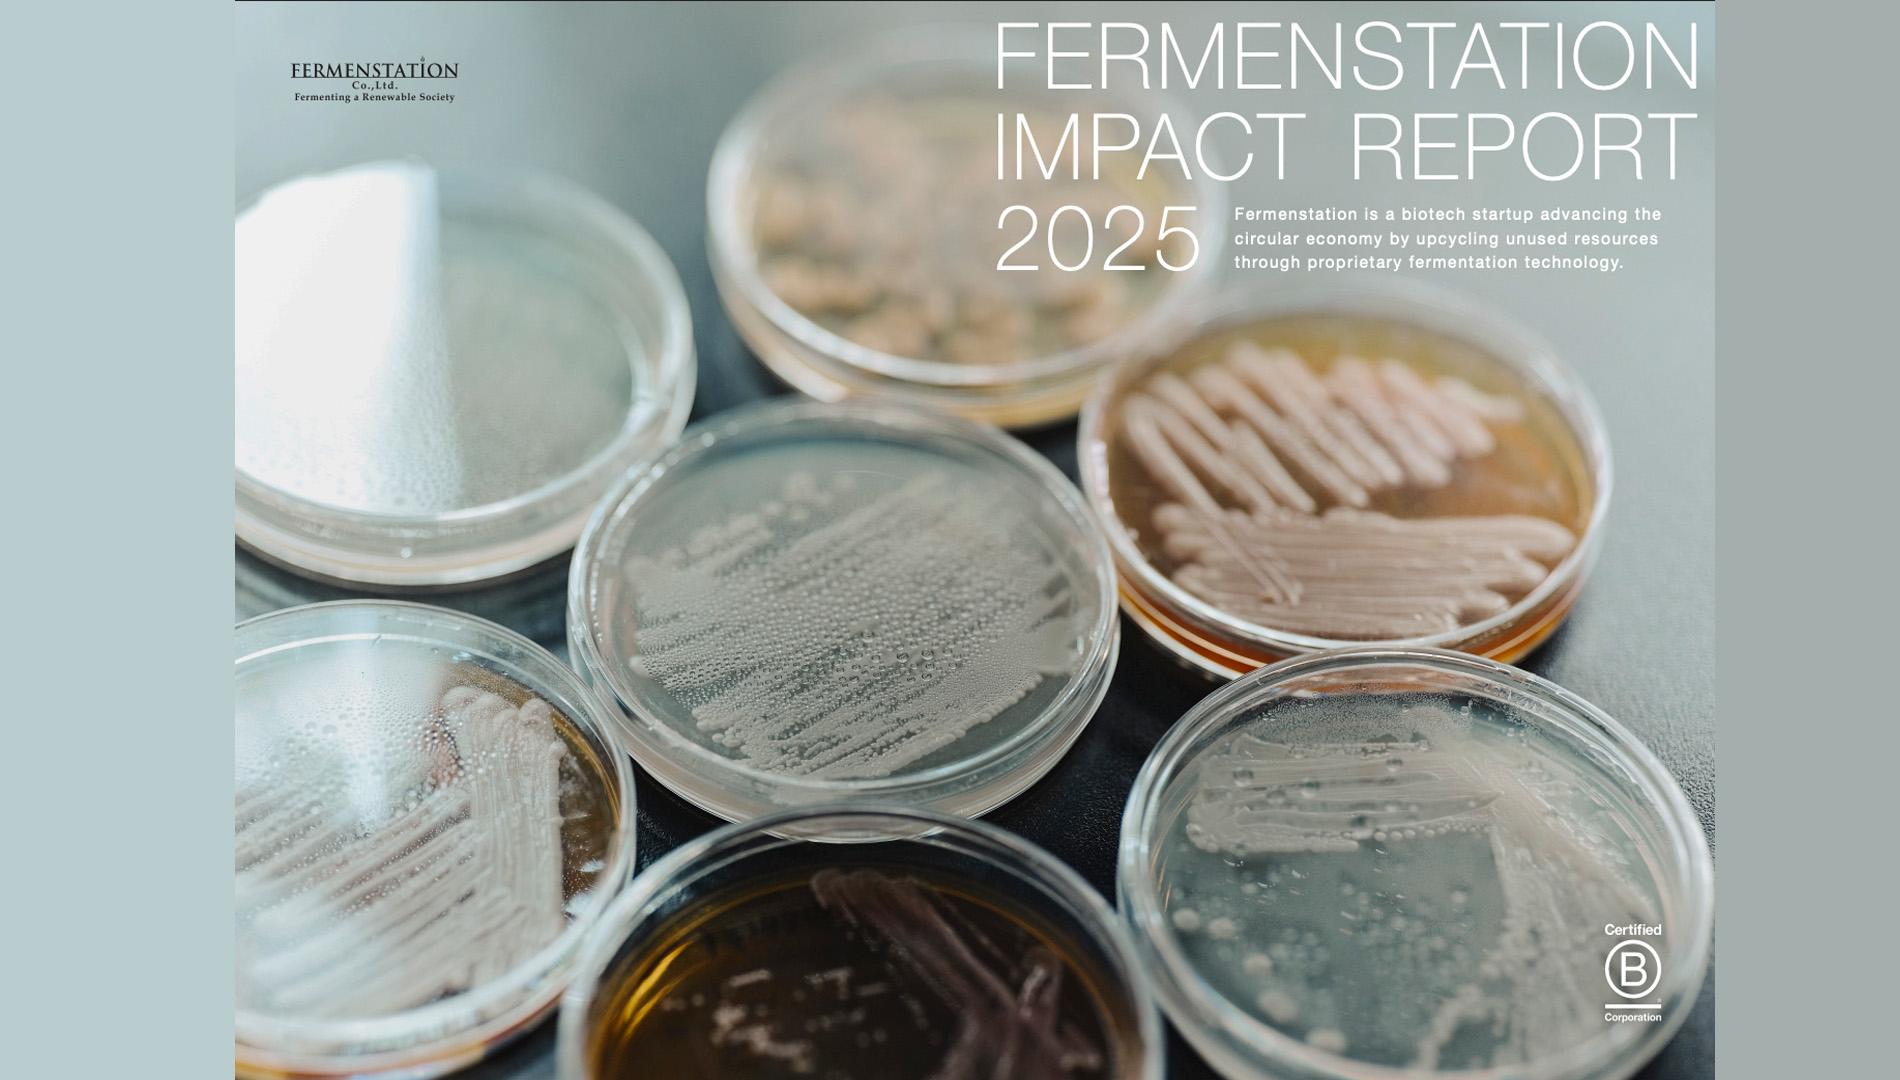

株式会社UnlocX 代表取締役CEO 田中宏隆が、株式会社ファーメンステーションが公開した「インパクトレポート2025」にコメントを寄稿しました。
ファーメンステーションは、独自の発酵アップサイクル技術を活用し、未利用資源を価値ある素材へと転換するバイオものづくりスタートアップです。今回公開されたレポートでは、事業性と社会性の両立に向けた取り組み、食領域への事業拡張、インパクト創出に向けた試行錯誤などが紹介されています。
UnlocXは、食の可能性を広げる共創型プロジェクトの推進を通じて、食産業の新たなエコシステムづくりに取り組んでいます。今後もチェンジメーカーやフードイノベーターの皆さまとともに、食の価値をUNLOCKし、未来の世代に誇れる食のあり方を共創してまいります。

参考情報
・関連リンク:https://prtimes.jp/main/html/rd/p/000000122.000051332.html
・「インパクトレポート2025」はこちらからご覧いただけます:https://fermenstation.co.jp/report/